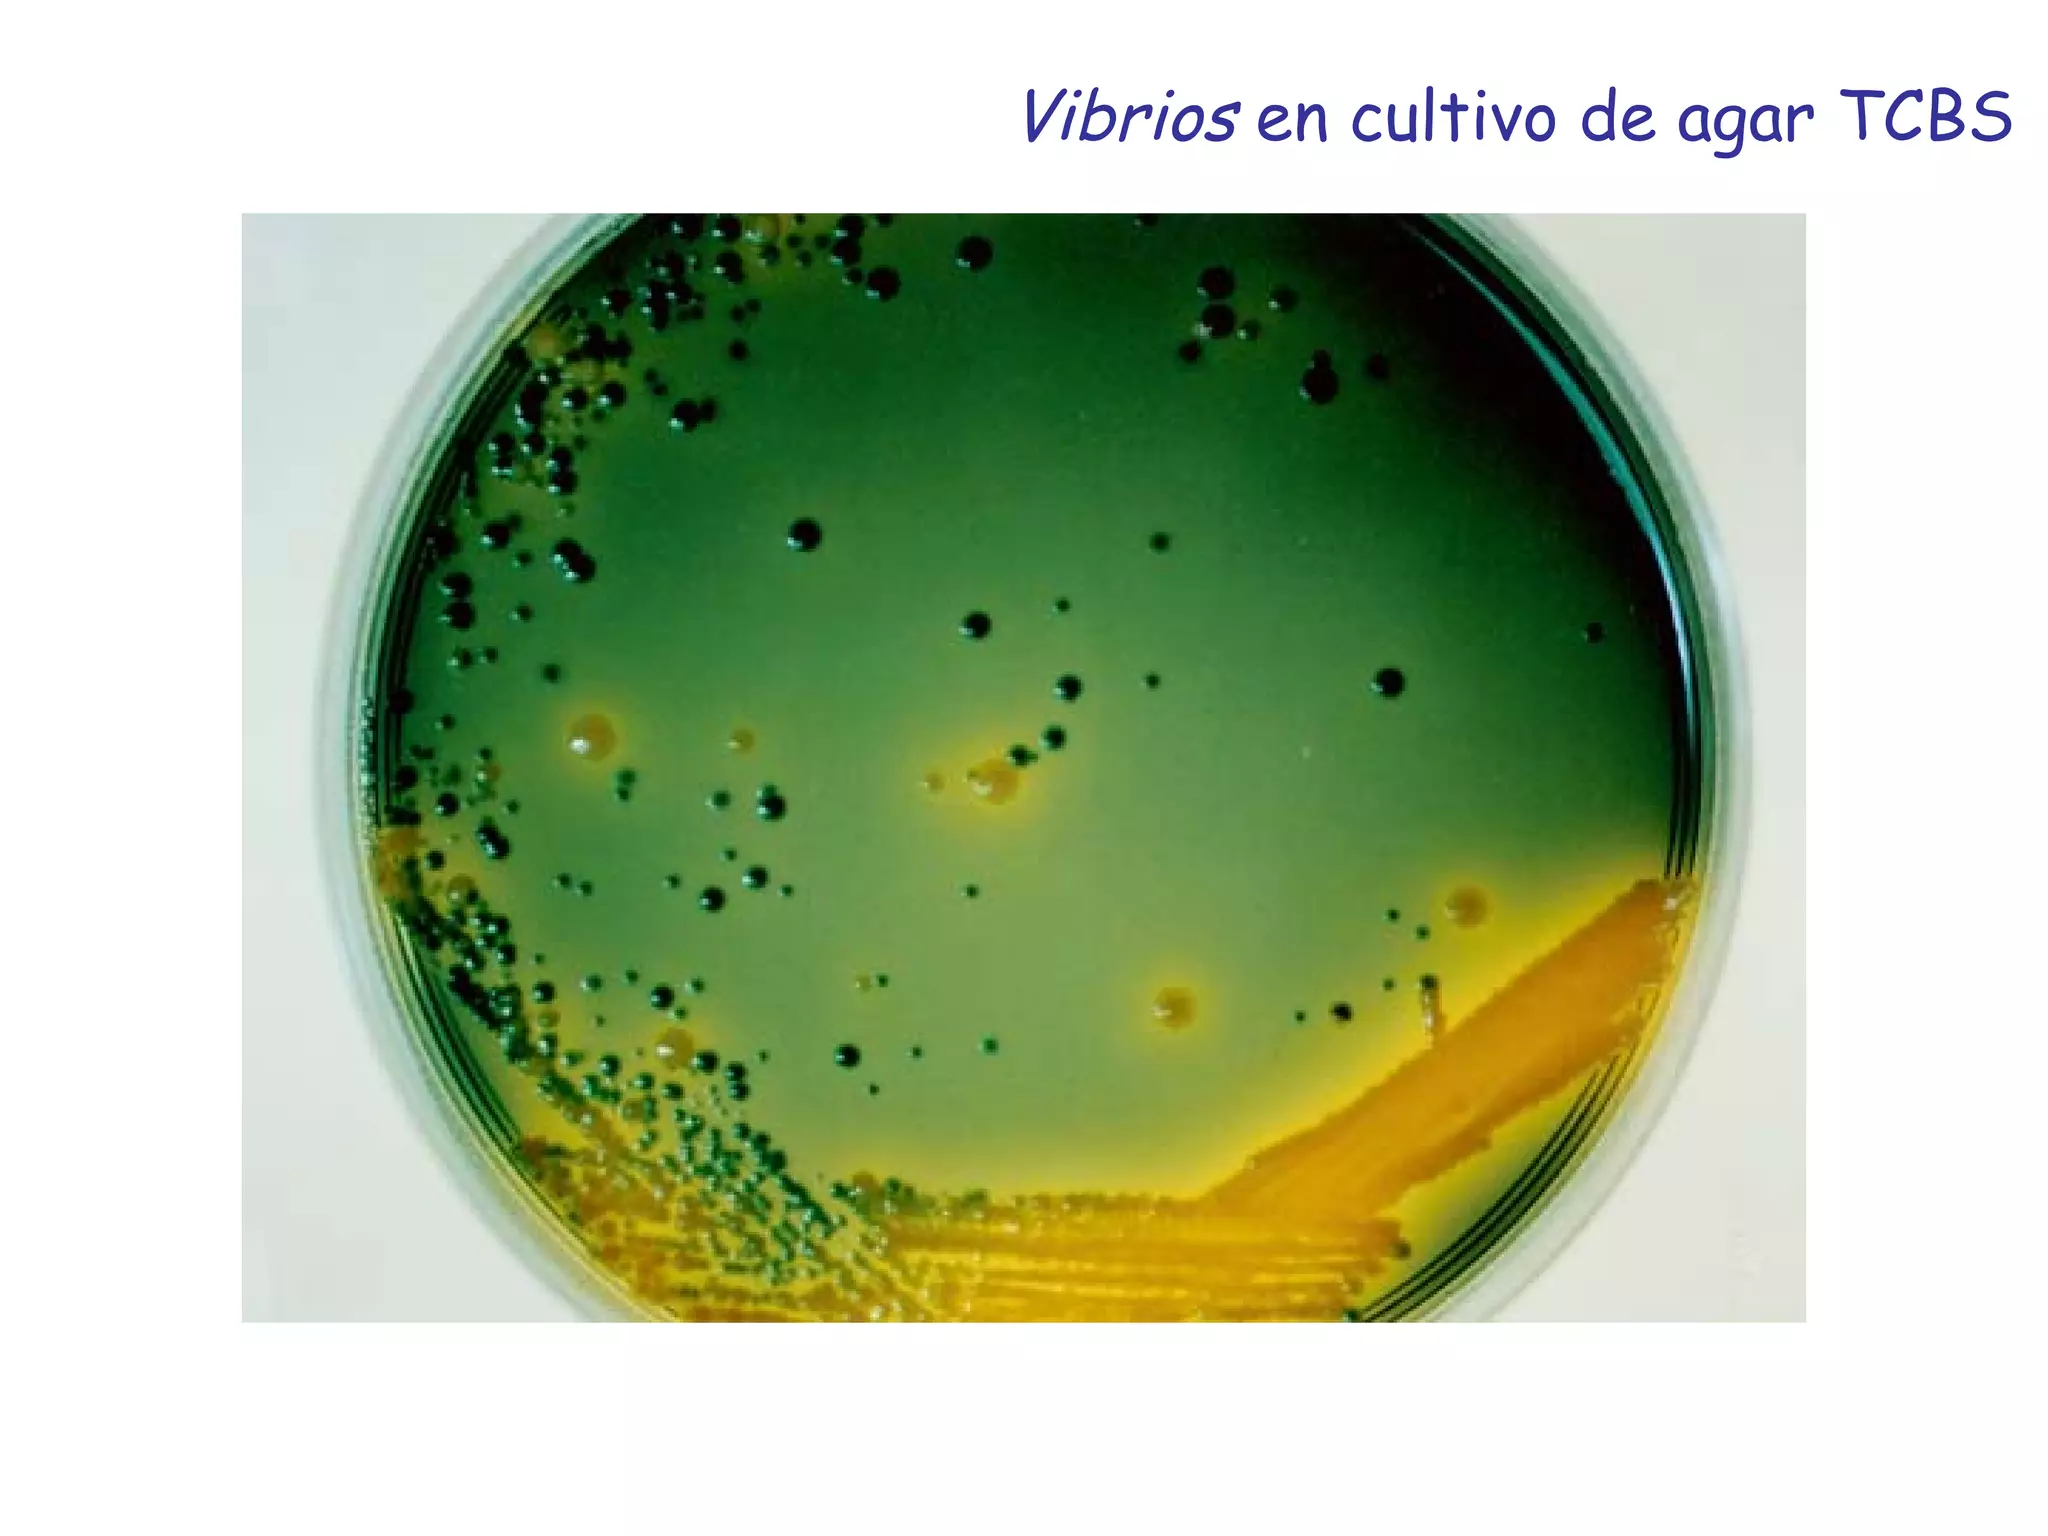
Vibrios  en cultivo de agar TCBS

El documento proporciona un resumen de los hitos más importantes en el desarrollo de la microbiología desde la primera observación de microorganismos en el siglo XVII hasta el desarrollo de la ingeniería genética y la biotecnología moderna en el siglo XX. También resume brevemente los descubrimientos clave de científicos pioneros como van Leeuwenhoek, Pasteur, Koch y otros en el establecimiento de los fundamentos de la microbiología.